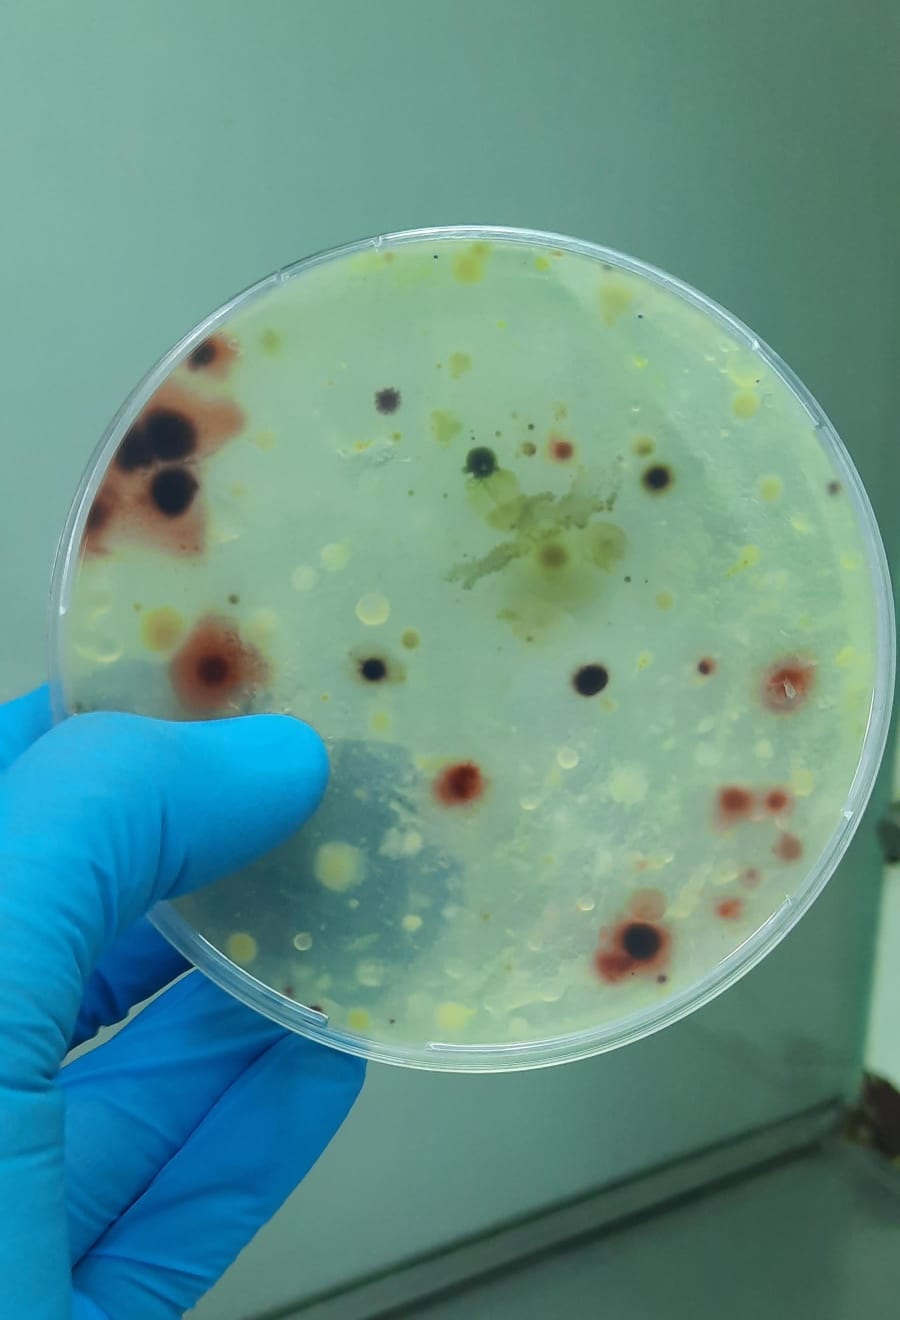
Advierten sobre el riesgo que corre el suelo de los cañaverales

FASES DEL TRABAJO. Lucrecia Ludueña y las muestras que se analizan.
FASES DEL TRABAJO. Lucrecia Ludueña y las muestras que se analizan.
Una investigación realizada por especialistas de la Estación Experimental Agroindustrial Obispo Colombres (Eeaoc) dejó en evidencia el serio riesgo que corre la salud de los suelos cuando se queman residuos de la cosecha de caña de azúcar. “El suelo pierde materia orgánica, se degrada su estructura, disminuye la retención de agua y se depende más de insumos externos para sostener la producción”, explica la biotecnóloga Lucrecia Ludueña.
Todo depende de cómo se maneja el llamado residuo agrícola de la cosecha (RAC). Cuando se lo deja como cobertura contribuye a enriquecer la calidad del suelo, pero al quemarlo el efecto es inverso. Los investigadores lo comprobaron con mediciones realizadas a lo largo de 10 años en parcelas ubicadas en Simoca.
La recomendación de Ludueña es clara: la quema de residuos está generando daños que en el largo plazo pueden ser muy serios. Ella trabajó bajo la dirección de Laura Tórtora, doctora en Ciencias Biológicas y docente de la UNT, en el marco del subprograma Agronomía de la Caña de Azúcar de la Eeaoc. Esta iniciativa es coordinada por el ingeniero agrónomo Javier Tonatto, con la participación del ingeniero Juan Fernández de Ullivarri y de los licenciados Leandro Hidalgo y María Núñez. Ludueña brindó detalles sobre los alcances de esta investigación y brindó sus conclusiones.

- ¿Cómo nació esta idea y quiénes la llevaron a cabo?
- Es una línea de investigación iniciada hace más de 10 años en la Estación Experimental, con el objetivo de entender cómo la quema de residuos de la cosecha de la caña de azúcar afectan la calidad del suelo. El trabajo lo llevamos adelante un equipo interdisciplinario de investigadores en microbiología, suelos y agronomía, evaluando parámetros biológicos que funcionan como indicadores de la salud del suelo.
- ¿En qué consistió la investigación? ¿Cuál fue la metodología elegida?
- Se instalaron parcelas de caña de azúcar en Simoca, donde se compararon dos prácticas: dejando los residuos en la superficie después de la cosecha o eliminándolos mediante una quema. En esas parcelas, que se mantienen bajo los mismos tratamientos desde hace más de una década, tomamos muestras de suelo y analizamos microorganismos benéficos (como Pseudomonas y bacterias fijadoras de nitrógeno) y actividades enzimáticas clave (beta-glucosidasa, nitrato reductasa, fosfatasa y FDA).
- ¿Cuáles son los efectos en el suelo? ¿Por qué es tan nocivo que disminuyan las poblaciones de microorganismos?
- Cuando se quema el RAC, observamos una caída significativa en las poblaciones de microorganismos benéficos y en la actividad enzimática. Esto es negativo porque son los responsables de reciclar nutrientes, formar materia orgánica, estabilizar el suelo y mantener su fertilidad. Sin ellos, el suelo pierde calidad y productividad en el tiempo. En cambio, cuando el RAC se conserva como cobertura, se genera un “mulch” que protege al suelo, mantiene la humedad, reduce la erosión y alimenta a la biota. Esto mejora la fertilidad natural y la resiliencia del sistema cañero.
- ¿Qué sucede con esas zonas afectadas por la quema de residuos en el mediano y largo plazo?
- Los efectos de la quema se acumulan con los años: el suelo pierde materia orgánica, se degrada su estructura, disminuye la retención de agua y se depende más de insumos externos para sostener la producción. En cambio, en los cañaverales donde se mantiene el RAC como cobertura se observan mejores condiciones biológicas y químicas, con suelos más estables y productivos a largo plazo.
- ¿Cuáles son las conclusiones del estudio y las recomendaciones que surgen?
- La conclusión es que dejar el RAC como cobertura es claramente más beneficioso que quemarlo. Conserva la biodiversidad microbiana, mantiene las enzimas del suelo activas y mejora la fertilidad y la sustentabilidad del sistema cañero. La recomendación es avanzar hacia la eliminación definitiva de la quema de residuos y promover la cosecha en verde con conservación del RAC, una práctica que aporta beneficios tanto ambientales como productivos.






























